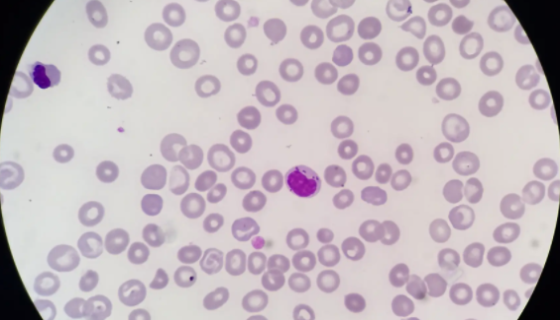
人骨髓增生异常综合征细胞株的处理方法与培养步骤！
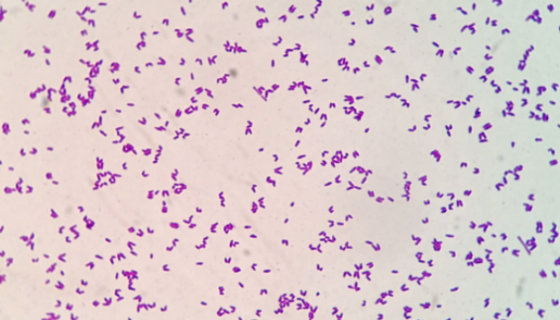
ATCC 492 密执安棍状杆菌密执安亚种菌株说明！

巴斯德毕赤酵母的培养方法与使用范围!
巴斯德毕赤酵母是Pichia属的微生物,原产地为中国。毕赤酵...
人骨髓增生异常综合征细胞株的处理方法与培养步骤!
人骨髓增生异常综合征细胞株的处理方法与培养步骤及注意事项有哪...

ATCC 43015 鸟分枝杆菌副结核亚种知识解析!
鸟分枝杆菌副结核亚种仅用于科学研究或者工业应用等非医疗目的不...

INT407人小肠上皮细胞的培养步骤与操作方法!
人小肠上皮细胞INT407细胞,又名Intestine 40...

黑曲霉的单层冻干管打管说明及注意事项!
黑曲霉,半知菌亚门,丝孢纲,丝孢目,丛梗孢科,曲霉属真菌中的...

肠道致病性大肠埃希氏菌——分析检测和质量控制
肠道致病性大肠埃希氏菌是Escherichia属的微生物,原...

草螺菌的形态特征与主要价值及打管说明!
草螺菌是Herbaspirillum属的微生物,原产地为中国...
ATCC 492 密执安棍状杆菌密执安亚种菌株说明!
密执安棍状杆菌,直或弯的细长杆菌,0.4—0.75nm×0....

CACO-2细胞专用培养基的生长特性及应用!
CACO-2细胞专用培养基经过长期测试,可保持Caco-2细...